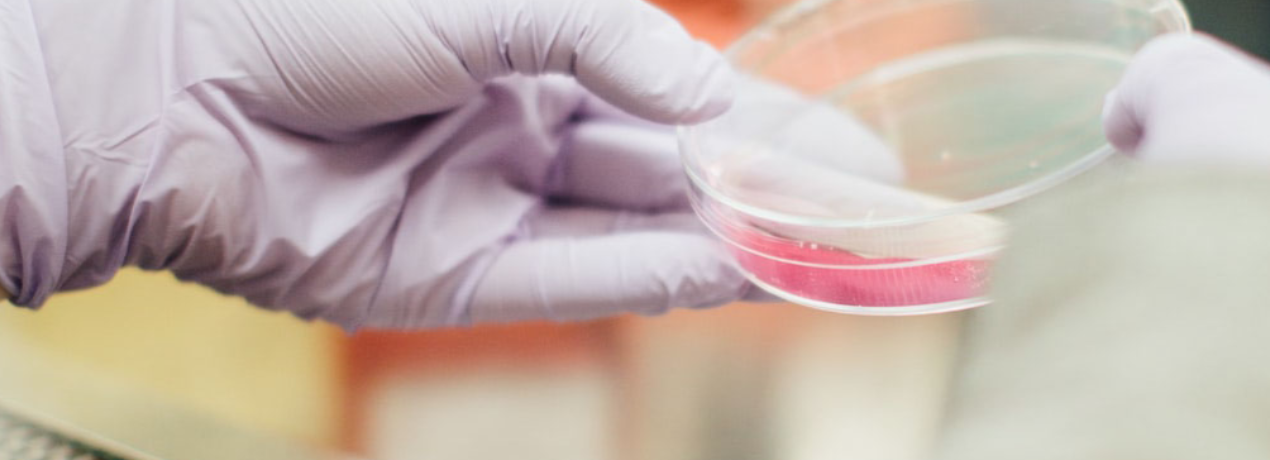

Ciencia, Tecnología e Innovación para los ODS en Iberoamérica
El seminario 'Ciencia, Tecnología e Innovación para el cumplimiento de los ODS en Iberoamérica' tiene como objetivo fomentar el diálogo entre analistas e instituciones encargadas de promover el flujo de conocimiento en pro del desarrollo sostenible en Iberoamérica. Los esfuerzos de la región iberoamericana en la generación y absorción de conocimiento resultan ser un elemento clave para el cumplimiento de los objetivos de desarrollo en el marco de la Agenda 2030. Una de las cuestiones fundamentales es avanzar en una mejor comprensión de las oportunidades de producción del conocimiento y transmisión en el marco de los sistemas nacionales de innovación y de la cooperación internacional.
Fecha: martes 19 de noviembre de 2019.
Hora: 10.00-14.00.
Confirmación de asistencia aquí.
Acreditaciones a medios en prensa@casamerica.es

10.00-11.30. Sesión de apertura.
- Aina Calvo, directora de la Agencia Española de Cooperación Internacional para el Desarrollo (AECID).
- José Antonio Sanahuja, director de la Fundación Carolina.
- Isabel Álvarez, directora del Instituto Complutense de Estudios Internacionales (ICEI).
- Mariano Jabonero, secretario general de la Organización de Estados Iberoamericanos para la Educación, la Ciencia y la Cultura (OEI).
10.30. Conferencia 'Generación y transferencia de conocimiento, ODS y desarrollo'.
A cargo de Gabriela Dutrénit, profesora de la Universidad Autónoma de México-Xochimilco.
11.30. Pausa Café.
12.00. Panel 'Internacionalización y cooperación en Ciencia, Tecnología e Investigación para el desarrollo'.
- Ángeles Valbuena, Departamento de Acción Tecnológica Exterior del Centro para el Desarrollo Tecnológico Industrial (CDTI).
- Miriam Ciscar Blat, jefa del Departamento de Cooperación Sectorial de AECID.
- Hugo Camacho, secretario general de la Fundación Carolina.
- Isabel Álvarez, directora del Instituto Complutense de Estudios Internacionales (ICEI).
13.00. Clausura.
A cargo de José Antonio Sanahuja, director de la Fundación Carolina.